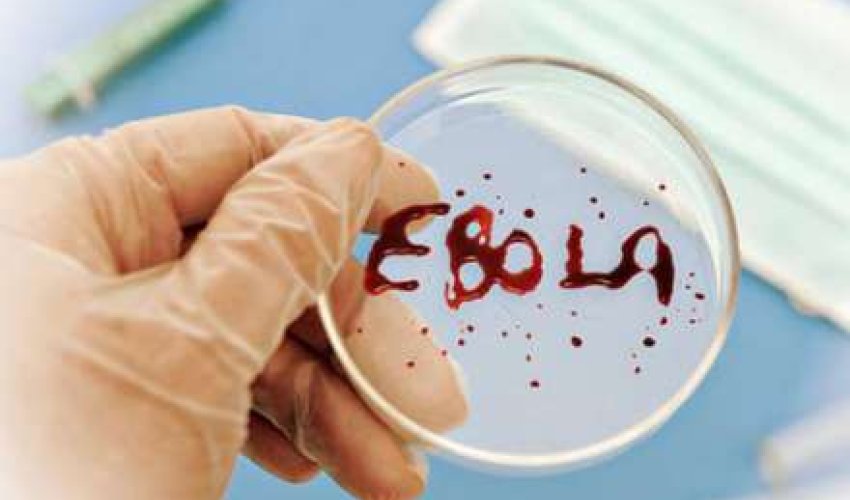
“Ebola” virusunu ABŞ icad edib - İDDİA

“Ebola” virusunu ABŞ icad edib - İDDİA
Şimali Koreya hakimiyyəti ABŞ-ı Afrika ərazisində bioloji silahı sınaqdan keçirməkdə və Ebola” xəstəliyini yaymaqda ittiham edib.
ANN.Az Oxu.Az-a istinadən xəbər verir ki, bu barədə The Independent nəşri məlumat yayıb.
KXDR-in Mərkəzi İnformasiya Agentliyinin yaydığı bəyanatda iddia edilir ki, ABŞ-ın keçmiş prezidenti Reyqanın köməkçisi Amerikanın bioloji müharibəyə başlamaq üçün "Ebola” virusunu icad etdiyini bildirib. Bəyanatda məlumatın mənbəyi "Roberts” adı ilə göstərilib. The Washington Post bu şəxsin iqtisadçı Pol Kreyq Roberts olduğunu ehtimal edir. Qeyd edək ki, Ebola epidemiyası ilə əlaqədar Şimali Koreya hazırda turistlərin ölkəyə girişinə qadağa qoyub. Ölkəyə daxil olan digər şəxslər isə dərhal karantinə götürülür.
ANN.Az
ANN.Az Oxu.Az-a istinadən xəbər verir ki, bu barədə The Independent nəşri məlumat yayıb.
KXDR-in Mərkəzi İnformasiya Agentliyinin yaydığı bəyanatda iddia edilir ki, ABŞ-ın keçmiş prezidenti Reyqanın köməkçisi Amerikanın bioloji müharibəyə başlamaq üçün "Ebola” virusunu icad etdiyini bildirib. Bəyanatda məlumatın mənbəyi "Roberts” adı ilə göstərilib. The Washington Post bu şəxsin iqtisadçı Pol Kreyq Roberts olduğunu ehtimal edir. Qeyd edək ki, Ebola epidemiyası ilə əlaqədar Şimali Koreya hazırda turistlərin ölkəyə girişinə qadağa qoyub. Ölkəyə daxil olan digər şəxslər isə dərhal karantinə götürülür.
ANN.Az




































 Foto
Foto 



 Video
Video 

